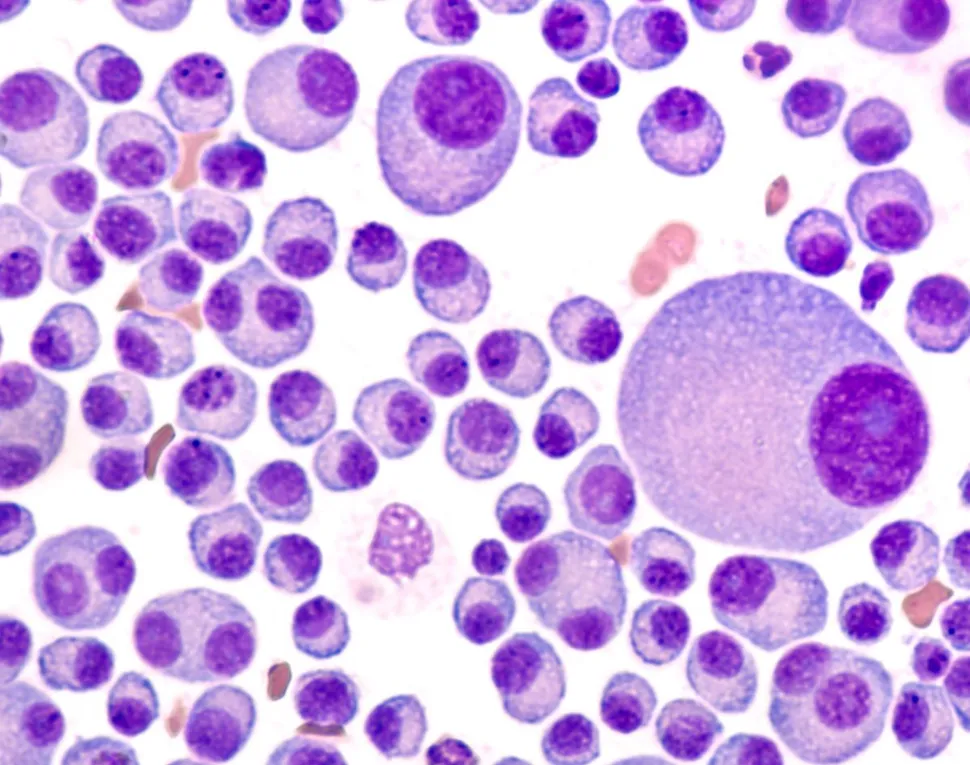
HealthTree University: Multiple Myeloma Basics Part 1 (1 of 3) image

HealthTree University: Multiple Myeloma Basics Part 1 (1 of 3)
Knowledge really is power. As a myeloma patient, it is critical that you become an active participant in your care! And you can’t do that unless you get educated about your myeloma.
Dr. Morie Gertz of the Mayo Clinic said “educated patients tend to have better outcomes, and I think they live longer.” We have created HealthTree University to help you get educated, become empowered when it comes to your disease, and get better outcomes.
If you register in HealthTree to use HealthTree University, you can save and keep track of your progress, get points for answering quiz questions, bookmark videos, take notes, earn prizes [COMING SOON], and get access to all the other features of HealthTree.
1.01 - What is multiple myeloma? (Drs. Landgren and Gertz)
What is multiple myeloma? Watch this excellent explanation of the basics of what multiple myeloma is.
Featuring:
- Ola Landgren, MD, PhD of Memorial Sloan Kettering Cancer Center
- Morie Gertz, MD, MACP of the Mayo Clinic
1.02 - What is multiple myeloma? (Kumar and Voorhees)
What is multiple myeloma? Watch another excellent explanation of the basics of what multiple myeloma is.
Featuring:
- Shaji Kumar, MD of the Mayo Clinic
- Peter Voorhees, MD of Levine Cancer Institute
1.03 - What is multiple myeloma? (Animated)
1.04 - What are the signs and symptoms of multiple myeloma?
The CRAB symptoms are a way to watch out for and be aware of myeloma.
Featuring:
- Suzanne Lentzsch, MD, PhD of Columbia University
1.05 - How long will I live with multiple myeloma, and is there a cure?
There has been so much progress in the past several years! Multiple experts weigh in on survival with multiple myeloma.
Featuring:
- Rafael Fonseca, MD of the Mayo Clinic
- Saad Usmani, MD, FACP of Levine Cancer Institute
- Natalie Callander, MD of University of Wisconsin
Want more?
We have over 200 HealthTree University videos online at university.healthtree.org! Learn the basics (and the not-so-basics) of myeloma from some of the top myeloma doctors in the world!
Other HealthTree University Classes:
- Myeloma Basics Part 1
- Myeloma Basics Part 2
- Myeloma Basics Part 3
- Building Your HealthCare Team
- Becoming an Empowered Patient
- Starting Myeloma Treatment
- Autologous Stem Cell Transplant (ASCT)
- Precursor Conditions
- Relapsed and Refractory MM Treatment
- Myeloma Bone Disease
- Testing, Monitoring MM Markers
- [BETA] Multiple Myeloma Genetics and Precision Medicine
- Classes of Myeloma Drugs
- [BETA] COVID-19 and Multiple Myeloma
Thanks to our HealthTree University sponsors!
Bristol Myers Squibb, Amgen, GSK, Takeda Oncology, Sanofi Genzyme, Janssen Oncology, Adaptive Biotechnologies, and Genentech
Knowledge really is power. As a myeloma patient, it is critical that you become an active participant in your care! And you can’t do that unless you get educated about your myeloma.
Dr. Morie Gertz of the Mayo Clinic said “educated patients tend to have better outcomes, and I think they live longer.” We have created HealthTree University to help you get educated, become empowered when it comes to your disease, and get better outcomes.
If you register in HealthTree to use HealthTree University, you can save and keep track of your progress, get points for answering quiz questions, bookmark videos, take notes, earn prizes [COMING SOON], and get access to all the other features of HealthTree.
1.01 - What is multiple myeloma? (Drs. Landgren and Gertz)
What is multiple myeloma? Watch this excellent explanation of the basics of what multiple myeloma is.
Featuring:
- Ola Landgren, MD, PhD of Memorial Sloan Kettering Cancer Center
- Morie Gertz, MD, MACP of the Mayo Clinic
1.02 - What is multiple myeloma? (Kumar and Voorhees)
What is multiple myeloma? Watch another excellent explanation of the basics of what multiple myeloma is.
Featuring:
- Shaji Kumar, MD of the Mayo Clinic
- Peter Voorhees, MD of Levine Cancer Institute
1.03 - What is multiple myeloma? (Animated)
1.04 - What are the signs and symptoms of multiple myeloma?
The CRAB symptoms are a way to watch out for and be aware of myeloma.
Featuring:
- Suzanne Lentzsch, MD, PhD of Columbia University
1.05 - How long will I live with multiple myeloma, and is there a cure?
There has been so much progress in the past several years! Multiple experts weigh in on survival with multiple myeloma.
Featuring:
- Rafael Fonseca, MD of the Mayo Clinic
- Saad Usmani, MD, FACP of Levine Cancer Institute
- Natalie Callander, MD of University of Wisconsin
Want more?
We have over 200 HealthTree University videos online at university.healthtree.org! Learn the basics (and the not-so-basics) of myeloma from some of the top myeloma doctors in the world!
Other HealthTree University Classes:
- Myeloma Basics Part 1
- Myeloma Basics Part 2
- Myeloma Basics Part 3
- Building Your HealthCare Team
- Becoming an Empowered Patient
- Starting Myeloma Treatment
- Autologous Stem Cell Transplant (ASCT)
- Precursor Conditions
- Relapsed and Refractory MM Treatment
- Myeloma Bone Disease
- Testing, Monitoring MM Markers
- [BETA] Multiple Myeloma Genetics and Precision Medicine
- Classes of Myeloma Drugs
- [BETA] COVID-19 and Multiple Myeloma
Thanks to our HealthTree University sponsors!
Bristol Myers Squibb, Amgen, GSK, Takeda Oncology, Sanofi Genzyme, Janssen Oncology, Adaptive Biotechnologies, and Genentech
about the author
Jennifer Ahlstrom
Myeloma survivor, patient advocate, wife, mom of 6. Believer that patients can contribute to cures by joining HealthTree Cure Hub and joining clinical research. Founder and CEO of HealthTree Foundation.
More on HealthTree Programs
Trending Articles
Upcoming Events

Get the Latest Multiple Myeloma Updates, Delivered to You.
By subscribing to the HealthTree newsletter, you'll receive the latest research, treatment updates, and expert insights to help you navigate your health.
Together we care.
Together we cure.










